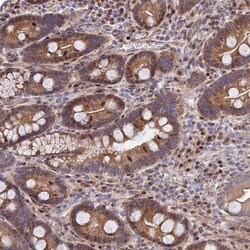
Invitrogen RPAP2 Polyclonal Antibody 100 &mu;L; Unconjugated:Antibodies,

missing translation for 'onlineSavingsMsg'
Learn More
Learn More
Invitrogen™ RPAP2 Polyclonal Antibody


Rabbit Polyclonal Antibody
Brand: Invitrogen™ PA561244
This item is not returnable.
View return policy
Description
Immunogen sequence: RCSRKAAGTK QTSTLKQEDA SKRKAELEAA VRKKIEFERK ALHIVEQLLE ENITEEFLME CGRFITPAHY SDVVDERSIV KLCGYPLCQK KLGI Highest antigen sequence identity to the following orthologs: Mouse - 79%, Rat - 76%.
RPAP2 belongs to the RNA Pol II-associated protein (RPAP) family, a set of proteins involved in human Pol II machinery. Recently it has been reported that RPAP2 is required for efficient transcription of snRNA genes by Pol II. siRNA-mediated knock down of RPAP2 caused defects in snRNA gene expression. (22137580).
Specifications
| RPAP2 | |
| Polyclonal | |
| Unconjugated | |
| Rpap2 | |
| AW060207; C1orf82; Putative RNA polymerase II subunit B1 CTD phosphatase RPAP2; RNA polymerase II associated protein 2; RNA polymerase II-associated protein 2; RPAP2; Rtr1 | |
| Rabbit | |
| Antigen affinity chromatography | |
| RUO | |
| 79871 | |
| Store at 4°C short term. For long term storage, store at -20°C, avoiding freeze/thaw cycles. | |
| Liquid |
| ChIP Assay, Immunohistochemistry (Paraffin), Western Blot, Immunocytochemistry | |
| 0.2 mg/mL | |
| PBS with 40% glycerol and 0.02% sodium azide; pH 7.2 | |
| Q8IXW5 | |
| Rpap2 | |
| Recombinant protein corresponding to Human RPAP2. Recombinant protein control fragment (Product #RP-99789). | |
| 100 μL | |
| Primary | |
| Human | |
| Antibody | |
| IgG |
Product Content Correction
Your input is important to us. Please complete this form to provide feedback related to the content on this product.
Product Title
Spot an opportunity for improvement?Share a Content Correction